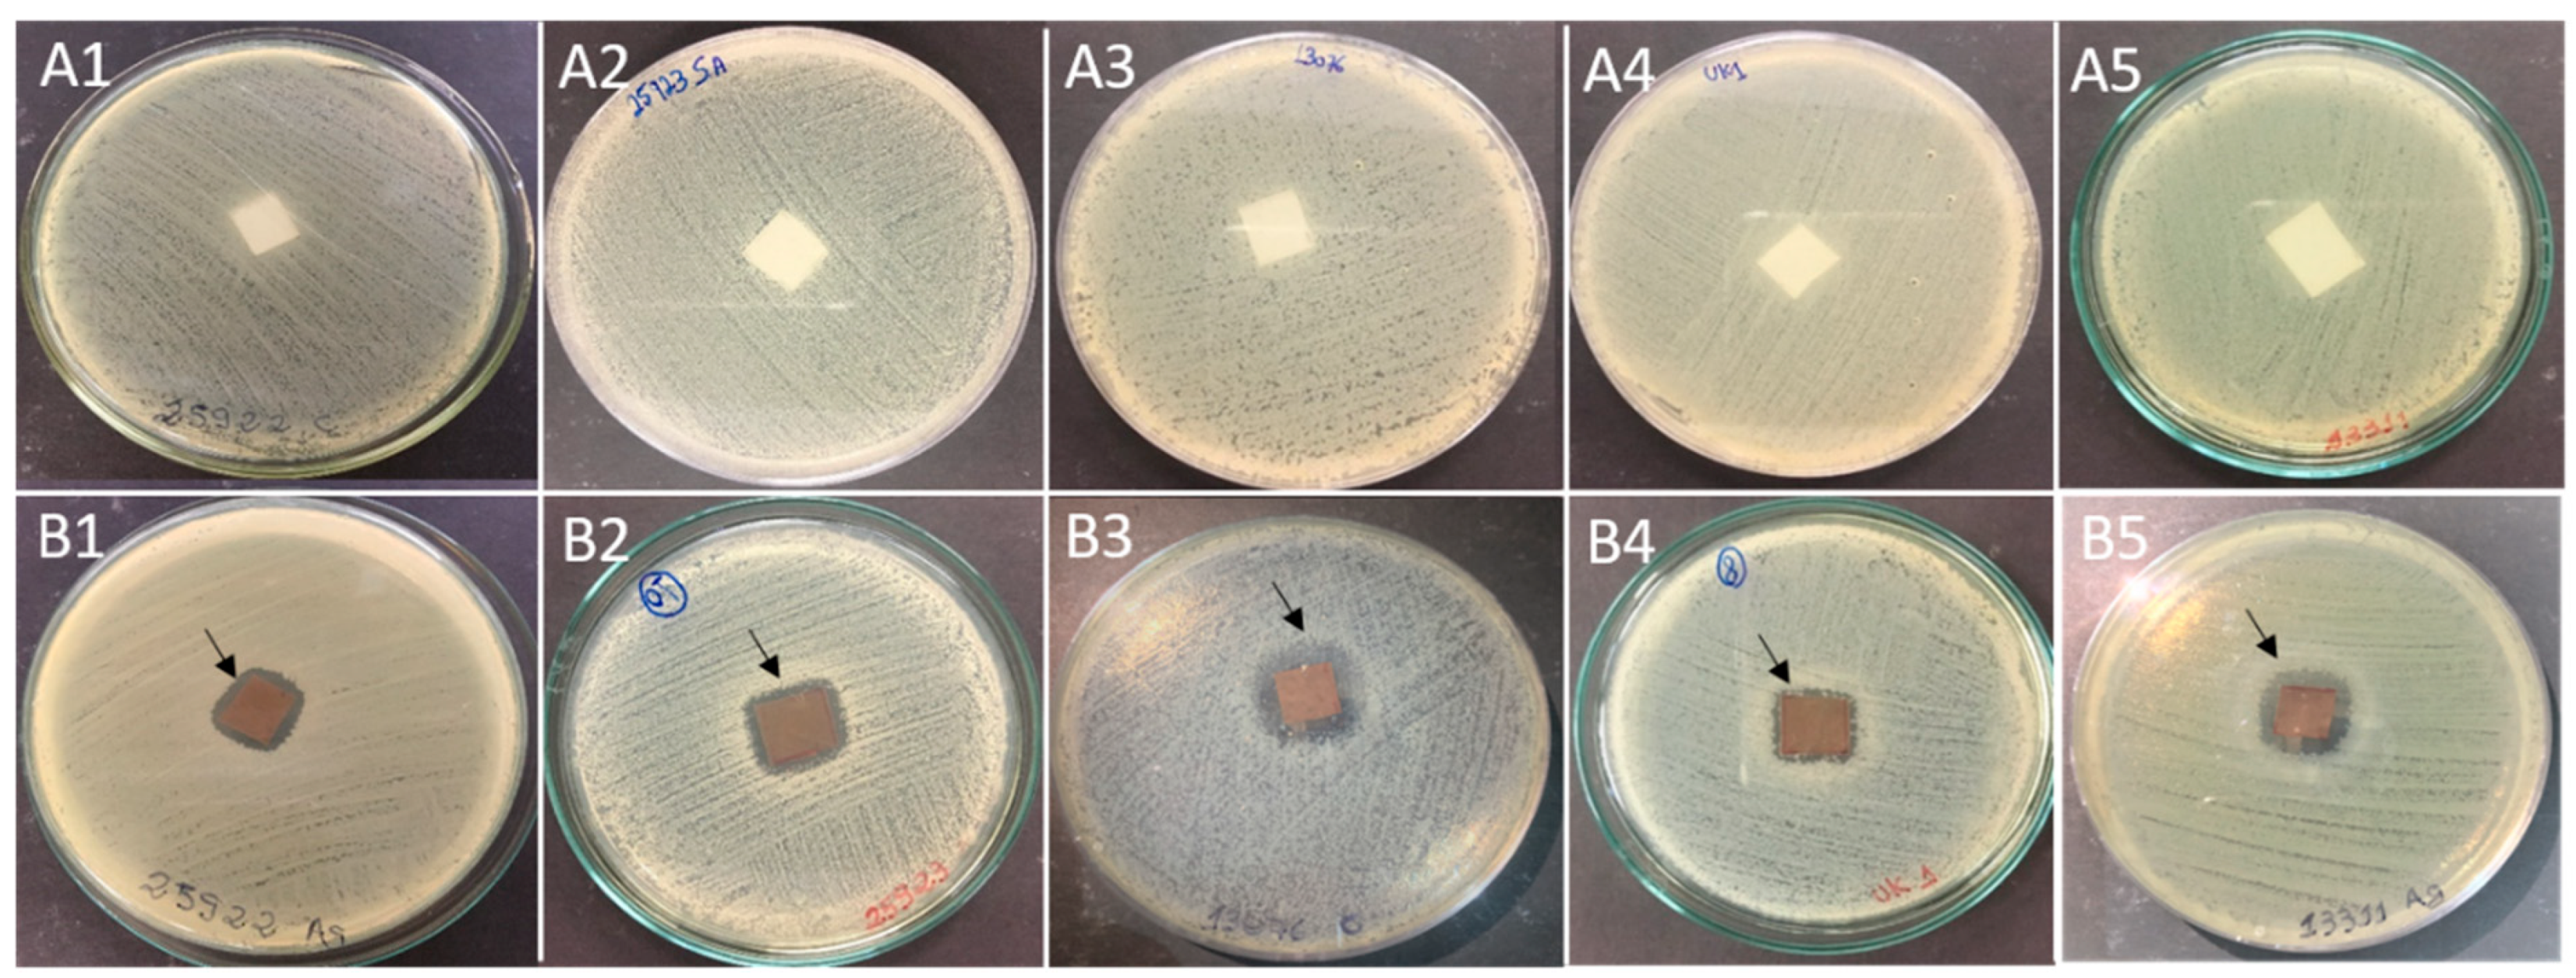

Antibacterial Activity of Biodegradable Films Incorporated with Biologically-Synthesized Silver Nanoparticles and the Evaluation of Their Migration to Chicken Meat
Abstract
1. Introduction
2. Results
2.1. Characterization of Bio-AgNPs
2.2. MIC and MBC Determination for Bio-AgNPs
2.3. Time-Kill Assay
2.4. Antimicrobial Tests Using Biodegradable Films with Bio-AgNPs
2.4.1. Agar Diffusion Assay
2.4.2. Quantification of Bacteria Inhibited by Bio-AgNPs Films
2.4.3. Growth Curve with Bio-AgNPs Films
3. Analysis of Silver Migration from Bio-AgNPs Films to Chicken Meat
4. Discussion
5. Materials and Methods
5.1. Bacterial Strains
5.2. Biogenic Silver Nanoparticles
5.3. Determination of Inhibitory and Bactericidal Concentrations of Bio-AgNPs
5.4. Time-Kill Assay of Bio-AgNPs
5.5. Preparation of Biodegradable Films with Bio-AgNPs
5.6. Antimicrobial Test Using Biodegradable Films with Bio-AgNPs
5.6.1. Agar Diffusion Assay
5.6.2. Qualitative Measurement of Bacteria Inhibition by Bio-AgNPs Films
5.6.3. Bacterial Growth Curve in Contact with Bio-AgNPs Films
5.7. Analysis of Silver Migration from Bio-AgNPs Films to Chicken Meat
5.8. Statistical Method
6. Conclusions
Supplementary Materials
Author Contributions
Funding
Institutional Review Board Statement
Informed Consent Statement
Data Availability Statement
Acknowledgments
Conflicts of Interest
References
- World Health Organization. WHO Estimates of the Global Burden of Foodborne Diseases; WHO: Geneva, Switzerland, 2015. [Google Scholar]
- Tang, S.; Orsi, R.H.; Luo, H.; Ge, C.; Zhang, G.; Baker, R.C.; Stevenson, A.; Wiedmann, M. Assessment and Comparison of Molecular Subtyping and Characterization Methods for Salmonella. Front. Microbiol. 2019, 10, 1591. [Google Scholar] [CrossRef] [PubMed]
- Acar, S.; Bulut, E.; Stasiewicz, M.J.; Soyer, Y. Genome Analysis of Antimicrobial Resistance, Virulence, and Plasmid Presence in Turkish Salmonella Serovar Infantis Isolates. Int. J. Food Microbiol. 2019, 307, 108275. [Google Scholar] [CrossRef] [PubMed]
- Wyrwa, J.; Barska, A. Innovations in the Food Packaging Market: Active Packaging. Eur. Food Res. Technol. 2017, 243, 1681–1692. [Google Scholar] [CrossRef]
- Valdés, A.; Burgos, N.; Jiménez, A.; Garrigós, M. Natural Pectin Polysaccharides as Edible Coatings. Coatings 2015, 5, 865–886. [Google Scholar] [CrossRef]
- Yeo, S.J.; Oh, M.J.; Kim, Y.; Weon, B.M.; Kwon, S.J.; Yoo, P.J. Controlled Synthesis of Solid-Shelled Non-Spherical and Faceted Microbubbles. Nanoscale 2022, 14, 12581–12588. [Google Scholar] [CrossRef]
- Shanmuganathan, R.; Karuppusamy, I.; Saravanan, M.; Muthukumar, H.; Ponnuchamy, K.; Ramkumar, V.S.; Pugazhendhi, A. Synthesis of Silver Nanoparticles and Their Biomedical Applications—A Comprehensive Review. Curr. Pharm. Des. 2019, 25, 2650–2660. [Google Scholar] [CrossRef]
- Silver, S.; Phung, L.T.; Silver, G. Silver as Biocides in Burn and Wound Dressings and Bacterial Resistance to Silver Compounds. J. Ind. Microbiol. Biotechnol. 2006, 33, 627–634. [Google Scholar] [CrossRef]
- Zhang, X.-F.; Liu, Z.-G.; Shen, W.; Gurunathan, S. Silver Nanoparticles: Synthesis, Characterization, Properties, Applications, and Therapeutic Approaches. Int. J. Mol. Sci. 2016, 17, 1534. [Google Scholar] [CrossRef]
- Ortega, F.; Arce, V.B.; Garcia, M.A. Nanocomposite Starch-Based Films Containing Silver Nanoparticles Synthesized with Lemon Juice as Reducing and Stabilizing Agent. Carbohydr. Polym. 2021, 252, 117208. [Google Scholar] [CrossRef]
- Ahmed, J.; Arfat, Y.A.; Bher, A.; Mulla, M.; Jacob, H.; Auras, R. Active Chicken Meat Packaging Based on Polylactide Films and Bimetallic Ag-Cu Nanoparticles and Essential Oil. J. Food Sci. 2018, 83, 1299–1310. [Google Scholar] [CrossRef]
- Ceballos, R.L.; von Bilderling, C.; Guz, L.; Bernal, C.; Famá, L. Effect of Greenly Synthetized Silver Nanoparticles on the Properties of Active Starch Films Obtained by Extrusion and Compression Molding. Carbohydr. Polym. 2021, 261, 117871. [Google Scholar] [CrossRef] [PubMed]
- Khatoon, N.; Sharma, Y.; Sardar, M.; Manzoor, N. Mode of Action and Anti-Candida Activity of Artemisia Annua Mediated-Synthesized Silver Nanoparticles. J. Mycol. Med. 2019, 29, 201–209. [Google Scholar] [CrossRef] [PubMed]
- Sackey, J.; Fell, A.; Ngilirabanga, J.B.; Razanamahandry, L.C.; Ntwampe, S.K.O.; Nkosi, M. Antibacterial Effect of Silver Nanoparticles Synthesised on a Polycarbonate Membrane. Mater. Today Proc. 2021, 36, 336–342. [Google Scholar] [CrossRef]
- Gandini, A.; Lacerda, T.M.; Carvalho, A.J.F.; Trovatti, E. Progress of Polymers from Renewable Resources: Furans, Vegetable Oils, and Polysaccharides. Chem. Rev. 2016, 116, 1637–1669. [Google Scholar] [CrossRef]
- Roopan, S.M. An Overview of Natural Renewable Bio-Polymer Lignin towards Nano and Biotechnological Applications. Int. J. Biol. Macromol. 2017, 103, 508–514. [Google Scholar] [CrossRef]
- De Medeiros, J.A.S.; Blick, A.P.; Galindo, M.V.; Alvim, I.D.; Yamashita, F.; Ueno, C.T.; Shirai, M.A.; Grosso, C.R.F.; Corradini, E.; Sakanaka, L.S. Incorporation of Oregano Essential Oil Microcapsules in Starch-Poly (Butylene Adipate Co-Terephthalate) (PBAT) Films. Macromol. Symp. 2019, 383, 1800052. [Google Scholar] [CrossRef]
- Muller, J.; González-Martínez, C.; Chiralt, A. Combination of Poly(Lactic) Acid and Starch for Biodegradable Food Packaging. Materials 2017, 10, 952. [Google Scholar] [CrossRef]
- Božanić, D.K.; Djoković, V.; Dimitrijević-Branković, S.; Krsmanović, R.; McPherson, M.; Nair, P.S.; Georges, M.K.; Radhakrishnan, T. Inhibition of Microbial Growth by Silver–Starch Nanocomposite Thin Films. J. Biomater. Sci. Polym. Ed. 2011, 22, 2343–2355. [Google Scholar] [CrossRef]
- Li, W.; Zhang, C.; Chi, H.; Li, L.; Lan, T.; Han, P.; Chen, H.; Qin, Y. Development of Antimicrobial Packaging Film Made from Poly(Lactic Acid) Incorporating Titanium Dioxide and Silver Nanoparticles. Molecules 2017, 22, 1170. [Google Scholar] [CrossRef]
- Artiaga, G.; Ramos, K.; Ramos, L.; Cámara, C.; Gómez-Gómez, M. Migration and Characterisation of Nanosilver from Food Containers by AF4-ICP-MS. Food Chem. 2015, 166, 76–85. [Google Scholar] [CrossRef]
- Ozaki, A.; Kishi, E.; Ooshima, T.; Hase, A.; Kawamura, Y. Contents of Ag and Other Metals in Food-Contact Plastics with Nanosilver or Ag Ion and Their Migration into Food Simulants. Food Addit. Contam. Part A 2016, 33, 1490–1498. [Google Scholar] [CrossRef] [PubMed]
- Sooklert, K.; Wongjarupong, A.; Cherdchom, S.; Wongjarupong, N.; Jindatip, D.; Phungnoi, Y.; Rojanathanes, R.; Sereemaspun, A. Molecular and Morphological Evidence of Hepatotoxicity after Silver Nanoparticle Exposure: A Systematic Review, In Silico, and Ultrastructure Investigation. Toxicol. Res. 2019, 35, 257–270. [Google Scholar] [CrossRef] [PubMed]
- Chopra, I. The Increasing Use of Silver-Based Products as Antimicrobial Agents: A Useful Development or a Cause for Concern? J. Antimicrob. Chemother. 2007, 59, 587–590. [Google Scholar] [CrossRef]
- Bocate, K.P.; Reis, G.F.; de Souza, P.C.; Oliveira Junior, A.G.; Durán, N.; Nakazato, G.; Furlaneto, M.C.; de Almeida, R.S.; Panagio, L.A. Antifungal Activity of Silver Nanoparticles and Simvastatin against Toxigenic Species of Aspergillus. Int. J. Food Microbiol. 2019, 291, 79–86. [Google Scholar] [CrossRef] [PubMed]
- Lara, H.H.; Ayala-Nuñez, N.V.; Ixtepan-Turrent, L.; Rodriguez-Padilla, C. Mode of Antiviral Action of Silver Nanoparticles against HIV-1. J. Nanobiotechnol. 2010, 8, 1. [Google Scholar] [CrossRef]
- Loo, Y.Y.; Rukayadi, Y.; Nor-Khaizura, M.-A.-R.; Kuan, C.H.; Chieng, B.W.; Nishibuchi, M.; Radu, S. In Vitro Antimicrobial Activity of Green Synthesized Silver Nanoparticles Against Selected Gram-Negative Foodborne Pathogens. Front. Microbiol. 2018, 9, 1555. [Google Scholar] [CrossRef]
- Mathew, S.; Raveendran, A.; Mathew, J.; Radhakrishnan, E.K. Antibacterial Effectiveness of Rice Water (Starch)-Capped Silver Nanoparticles Fabricated Rapidly in the Presence of Sunlight. Photochem. Photobiol. 2019, 95, 627–634. [Google Scholar] [CrossRef]
- Scandorieiro, S.; de Camargo, L.C.; Lancheros, C.A.C.; Yamada-Ogatta, S.F.; Nakamura, C.V.; de Oliveira, A.G.; Andrade, C.G.T.J.; Duran, N.; Nakazato, G.; Kobayashi, R.K.T. Synergistic and Additive Effect of Oregano Essential Oil and Biological Silver Nanoparticles against Multidrug-Resistant Bacterial Strains. Front. Microbiol. 2016, 7, 760. [Google Scholar] [CrossRef]
- Sheikholeslami, S.; Mousavi, S.E.; Ahmadi Ashtiani, H.R.; Hosseini Doust, S.R.; Mahdi Rezayat, S. Antibacterial Activity of Silver Nanoparticles and Their Combination with Zataria Multiflora Essential Oil and Methanol Extract. Jundishapur J. Microbiol. 2016, 9, e36070. [Google Scholar] [CrossRef]
- Zarei, M.; Jamnejad, A.; Khajehali, E. Antibacterial Effect of Silver Nanoparticles Against Four Foodborne Pathogens. Jundishapur J. Microbiol. 2014, 7, e8720. [Google Scholar] [CrossRef]
- Sinsinwar, S.; Sarkar, M.K.; Suriya, K.R.; Nithyanand, P.; Vadivel, V. Use of Agricultural Waste (Coconut Shell) for the Synthesis of Silver Nanoparticles and Evaluation of Their Antibacterial Activity against Selected Human Pathogens. Microb. Pathog. 2018, 124, 30–37. [Google Scholar] [CrossRef] [PubMed]
- Cardozo, V.F.; Oliveira, A.G.; Nishio, E.K.; Perugini, M.R.; Andrade, C.G.; Silveira, W.D.; Durán, N.; Andrade, G.; Kobayashi, R.K.; Nakazato, G. Antibacterial Activity of Extracellular Compounds Produced by a Pseudomonas Strain against Methicillin-Resistant Staphylococcus Aureus (MRSA) Strains. Ann. Clin. Microbiol. Antimicrob. 2013, 12, 12. [Google Scholar] [CrossRef] [PubMed]
- Longhi, C.; Santos, J.P.; Morey, A.T.; Marcato, P.D.; Durán, N.; Pinge-Filho, P.; Nakazato, G.; Yamada-Ogatta, S.F.; Yamauchi, L.M. Combination of Fluconazole with Silver Nanoparticles Produced by Fusarium oxysporum Improves Antifungal Effect against Planktonic Cells and Biofilm of Drug-Resistant Candida albicans. Med. Mycol. 2016, 54, 428–432. [Google Scholar] [CrossRef] [PubMed]
- Agnihotri, S.; Mukherji, S.; Mukherji, S. Size-Controlled Silver Nanoparticles Synthesized over the Range 5–100 Nm Using the Same Protocol and Their Antibacterial Efficacy. RSC Adv. 2014, 4, 3974–3983. [Google Scholar] [CrossRef]
- Morones, J.R.; Elechiguerra, J.L.; Camacho, A.; Holt, K.; Kouri, J.B.; Ramírez, J.T.; Yacaman, M.J. The Bactericidal Effect of Silver Nanoparticles. Nanotechnology 2005, 16, 2346–2353. [Google Scholar] [CrossRef]
- Durán, N.; Nakazato, G.; Seabra, A.B. Antimicrobial Activity of Biogenic Silver Nanoparticles, and Silver Chloride Nanoparticles: An Overview and Comments. Appl. Microbiol. Biotechnol. 2016, 100, 6555–6570. [Google Scholar] [CrossRef]
- Lara, H.H.; Ayala-Núñez, N.V.; Ixtepan Turrent, L.d.C.; Rodríguez Padilla, C. Bactericidal Effect of Silver Nanoparticles against Multidrug-Resistant Bacteria. World J. Microbiol. Biotechnol. 2010, 26, 615–621. [Google Scholar] [CrossRef]
- Kurtz, J.R.; Goggins, J.A.; McLachlan, J.B. Salmonella Infection: Interplay between the Bacteria and Host Immune System. Immunol. Lett. 2017, 190, 42–50. [Google Scholar] [CrossRef]
- Gozi, K.S.; Froes, J.R.; Deus Ajude, L.P.T.; da Silva, C.R.; Baptista, R.S.; Peiró, J.R.; Marinho, M.; Mendes, L.C.N.; Nogueira, M.C.L.; Casella, T. Dissemination of Multidrug-Resistant Commensal Escherichia Coli in Feedlot Lambs in Southeastern Brazil. Front. Microbiol. 2019, 10, 1394. [Google Scholar] [CrossRef]
- Koga, V.L.; Scandorieiro, S.; Vespero, E.C.; Oba, A.; de Brito, B.G.; de Brito, K.C.T.; Nakazato, G.; Kobayashi, R.K.T. Comparison of Antibiotic Resistance and Virulence Factors among Escherichia coli Isolated from Conventional and Free-Range Poultry. Biomed Res. Int. 2015, 2015, 618752. [Google Scholar] [CrossRef]
- Rubin, J.E.; Ekanayake, S.; Fernando, C. Carbapenemase-Producing Organism in Food, 2014. Emerg. Infect. Dis. 2014, 20, 1264–1265. [Google Scholar] [CrossRef] [PubMed]
- Oh, J.-H.; Park, M.-K. Recent Trends in Salmonella Outbreaks and Emerging Technology for Biocontrol of Salmonella Using Phages in Foods: A Review. J. Microbiol. Biotechnol. 2017, 27, 2075–2088. [Google Scholar] [CrossRef] [PubMed]
- Olmos, D.; Pontes-Quero, G.; Corral, A.; González-Gaitano, G.; González-Benito, J. Preparation and Characterization of Antimicrobial Films Based on LDPE/Ag Nanoparticles with Potential Uses in Food and Health Industries. Nanomaterials 2018, 8, 60. [Google Scholar] [CrossRef] [PubMed]
- Qing, Y.; Cheng, L.; Li, R.; Liu, G.; Zhang, Y.; Tang, X.; Wang, J.; Liu, H.; Qin, Y. Potential Antibacterial Mechanism of Silver Nanoparticles and the Optimization of Orthopedic Implants by Advanced Modification Technologies. Int. J. Nanomed. 2018, 13, 3311–3327. [Google Scholar] [CrossRef]
- De Moura, M.R.; Lorevice, M.V.; Mattoso, L.H.C.; Zucolotto, V. Highly Stable, Edible Cellulose Films Incorporating Chitosan Nanoparticles. J. Food Sci. 2011, 76, N25–N29. [Google Scholar] [CrossRef]
- Abreu, A.S.; Oliveira, M.; de Sá, A.; Rodrigues, R.M.; Cerqueira, M.A.; Vicente, A.A.; Machado, A.V. Antimicrobial Nanostructured Starch Based Films for Packaging. Carbohydr. Polym. 2015, 129, 127–134. [Google Scholar] [CrossRef]
- Patra, J.K.; Baek, K.-H. Antibacterial Activity and Synergistic Antibacterial Potential of Biosynthesized Silver Nanoparticles against Foodborne Pathogenic Bacteria along with Its Anticandidal and Antioxidant Effects. Front. Microbiol. 2017, 8, 167. [Google Scholar] [CrossRef]
- Bondarenko, O.; Ivask, A.; Käkinen, A.; Kurvet, I.; Kahru, A. Particle-Cell Contact Enhances Antibacterial Activity of Silver Nanoparticles. PLoS ONE 2013, 8, e64060. [Google Scholar] [CrossRef]
- Vishnupriya, S.; Chaudhari, K.; Jagannathan, R.; Pradeep, T. Single-Cell Investigations of Silver Nanoparticle-Bacteria Interactions. Part. Part. Syst. Charact. 2013, 30, 1056–1062. [Google Scholar] [CrossRef]
- Kim, J.S.; Kuk, E.; Yu, K.N.; Kim, J.-H.; Park, S.J.; Lee, H.J.; Kim, S.H.; Park, Y.K.; Park, Y.H.; Hwang, C.-Y.; et al. Antimicrobial Effects of Silver Nanoparticles. Nanomed. Nanotechnol. Biol. Med. 2007, 3, 95–101. [Google Scholar] [CrossRef]
- Xu, H.; Qu, F.; Xu, H.; Lai, W.; Andrew Wang, Y.; Aguilar, Z.P.; Wei, H. Role of Reactive Oxygen Species in the Antibacterial Mechanism of Silver Nanoparticles on Escherichia Coli O157:H7. BioMetals 2012, 25, 45–53. [Google Scholar] [CrossRef] [PubMed]
- Durán, N.; Durán, M.; de Jesus, M.B.; Seabra, A.B.; Fávaro, W.J.; Nakazato, G. Silver Nanoparticles: A New View on Mechanistic Aspects on Antimicrobial Activity. Nanomed. Nanotechnol. Biol. Med. 2016, 12, 789–799. [Google Scholar] [CrossRef] [PubMed]
- Yuan, Z.; Li, J.; Cui, L.; Xu, B.; Zhang, H.; Yu, C.-P. Interaction of Silver Nanoparticles with Pure Nitrifying Bacteria. Chemosphere 2013, 90, 1404–1411. [Google Scholar] [CrossRef]
- Scandorieiro, S.; Rodrigues, B.C.D.; Nishio, E.K.; Panagio, L.A.; de Oliveira, A.G.; Durán, N.; Nakazato, G.; Kobayashi, R.K.T. Biogenic Silver Nanoparticles Strategically Combined With Origanum Vulgare Derivatives: Antibacterial Mechanism of Action and Effect on Multidrug-Resistant Strains. Front. Microbiol. 2022, 13, 1083. [Google Scholar] [CrossRef] [PubMed]
- Lok, C.-N.; Ho, C.-M.; Chen, R.; He, Q.-Y.; Yu, W.-Y.; Sun, H.; Tam, P.K.-H.; Chiu, J.-F.; Che, C.-M. Silver Nanoparticles: Partial Oxidation and Antibacterial Activities. J. Biol. Inorg. Chem. 2007, 12, 527–534. [Google Scholar] [CrossRef]
- Echegoyen, Y.; Nerín, C. Nanoparticle Release from Nano-Silver Antimicrobial Food Containers. Food Chem. Toxicol. 2013, 62, 16–22. [Google Scholar] [CrossRef]
- Gallocchio, F.; Cibin, V.; Biancotto, G.; Roccato, A.; Muzzolon, O.; Carmen, L.; Simone, B.; Manodori, L.; Fabrizi, A.; Patuzzi, I.; et al. Testing Nano-Silver Food Packaging to Evaluate Silver Migration and Food Spoilage Bacteria on Chicken Meat. Food Addit. Contam. Part A 2016, 33, 1063–1071. [Google Scholar] [CrossRef]
- EN-1186-1; Materials and Articles in Contact with Foodstuffs—Plastics—Part 1: Guide to the Selection of Conditions and Test Methods for Overall Migration. British Standards Institution: London, UK, 2002.
- Lambré, C.; Barat Baviera, J.M.; Bolognesi, C.; Chesson, A.; Cocconcelli, P.S.; Crebelli, R.; Gott, D.M.; Grob, K.; Lampi, E.; Mengelers, M.; et al. Safety Assessment of the Substance Silver Nanoparticles for Use in Food Contact Materials. EFSA J. 2021, 19, e06790. [Google Scholar] [CrossRef]
- Figueiredo, E.; Ribeiro, J.; Nishio, E.; Scandorieiro, S.; Costa, A.; Cardozo, V.; de Oliveira, A.; Durán, N.; Panagio, L.; Kobayashi, R.; et al. New Approach For Simvastatin As An Antibacterial: Synergistic Effect With Bio-Synthesized Silver Nanoparticles Against Multidrug-Resistant Bacteria. Int. J. Nanomed. 2019, 14, 7975–7985. [Google Scholar] [CrossRef]
- Wang, J.; Che, B.; Zhang, L.W.; Dong, G.; Luo, Q.; Xin, L. Comparative Genotoxicity of Silver Nanoparticles in Human Liver HepG2 and Lung Epithelial A549 Cells. J. Appl. Toxicol. 2017, 37, 495–501. [Google Scholar] [CrossRef]
- Arruda da Silva Sanfelice, R.; Silva, T.F.; Tomiotto-Pellissier, F.; Bortoleti, B.T.d.S.; Lazarin-Bidóia, D.; Scandorieiro, S.; Nakazato, G.; de Barros, L.D.; Garcia, J.L.; Verri, W.A.; et al. Biogenic Silver Nanoparticles Reduce Toxoplasma Gondii Infection and Proliferation in RAW 264.7 Macrophages by Inducing Tumor Necrosis Factor-Alpha and Reactive Oxygen Species Production in the Cells. Microbes Infect. 2022, 24, 104971. [Google Scholar] [CrossRef] [PubMed]
- Machado, L.F.; Sanfelice, R.A.; Bosqui, L.R.; Assolini, J.P.; Scandorieiro, S.; Navarro, I.T.; Depieri Cataneo, A.H.; Wowk, P.F.; Nakazato, G.; Bordignon, J.; et al. Biogenic Silver Nanoparticles Reduce Adherence, Infection, and Proliferation of Toxoplasma Gondii RH Strain in HeLa Cells without Inflammatory Mediators Induction. Exp. Parasitol. 2020, 211, 107853. [Google Scholar] [CrossRef]
- Larese Filon, F.; Mauro, M.; Adami, G.; Bovenzi, M.; Crosera, M. Nanoparticles Skin Absorption: New Aspects for a Safety Profile Evaluation. Regul. Toxicol. Pharmacol. 2015, 72, 310–322. [Google Scholar] [CrossRef] [PubMed]
- de Lima, R.; Seabra, A.B.; Durán, N. Silver Nanoparticles: A Brief Review of Cytotoxicity and Genotoxicity of Chemically and Biogenically Synthesized Nanoparticles. J. Appl. Toxicol. 2012, 32, 867–879. [Google Scholar] [CrossRef] [PubMed]
- Durán, N.; Marcato, P.D.; Alves, O.L.; De Souza, G.I.; Esposito, E. Mechanistic Aspects of Biosynthesis of Silver Nanoparticles by Several Fusarium Oxysporum Strains. J. Nanobiotechnol. 2005, 3, 8. [Google Scholar] [CrossRef]
- Clinical Laboratory Standards Institute. Methods for Dilution Antimicrobial Susceptibility Tests for Bacteria That Grow Aerobically; Clinical and Laboratory Standards Institute: Wayne, PA, USA, 2015; p. 35. [Google Scholar]
- Clinical and Laboratory Standards Institute. Performance Standards for Antimicrobial Susceptibility Testing; 23rd Informational Supplement, CLSI Document M100-S23; Clinical and Laboratory Standards Institute: Wayne, PA, USA, 2013. [Google Scholar]
- M26-A; Methods for Determining Bactericidal Activity of Antimicrobial Agents. Clinical and Laboratory Standards Institute: Wayne, PA, USA, 1999.
- Alves, L.C.; Wood, C.M. The Chronic Effects of Dietary Lead in Freshwater Juvenile Rainbow Trout (Oncorhynchus mykiss) Fed Elevated Calcium Diets. Aquat. Toxicol. 2006, 78, 217–232. [Google Scholar] [CrossRef]

| Bacteria | MIC (µg/mL) | MBC (µg/mL) |
|---|---|---|
| E. coli ATCC 25922 | 4.24 | 4.24 |
| S. aureus ATCC 25923 | 16.98 | 16.98 |
| S. Enteritidis ATCC 13076 | 8.49 | 8.49 |
| S. Typhimurium UK-1 ATCC 68169 S. Typhimurium ATCC 13311 | 8.49 4.24 | 8.49 8.49 |
| S. Saint Paul 09 | 8.49 | 8.49 |
| S. Saint Paul 10 | 8.49 | 8.49 |
| S. Saint Paul 11 | 8.49 | 16.98 |
| S. Saint Paul 12 | 16.98 | 16.98 |
| S. Saint Paul 13 | 8.49 | 8.49 |
| S. Enteritidis 92 | 8.49 | 8.49 |
| S. Enteritidis 02 | 8.49 | 8.49 |
| S. Enteritidis 06 | 8.49 | 8.49 |
| S. Seftenberg 14 | 16.98 | 16.98 |
| S. Seftenberg 15 | 16.98 | 16.98 |
| S. Seftenberg 16 | 8.49 | 16.98 |
| S. Seftenberg 17 | 8.49 | 8.49 |
| S. Seftenberg 18 | 8.49 | 8.49 |
| S. Seftenberg 19 | 8.49 | 16.98 |
| S. Kentucky 20 | 16.98 | 16.98 |
| S. Kentucky 21 | 8.49 | 8.49 |
| S. Kentucky 22 | 16.98 | 16.98 |
| S. Kentucky 25 | 16.98 | 16.98 |
| Bacteria | Bacterial Growth | Maximum Bacterial Concentration Inhibited by Bio-AgNPs Films (CFU/cm2) | |
|---|---|---|---|
| Bio-AgNPs Films | Films without Bio-AgNPs | ||
| E. coli ATCC 25922 | − | + | 105 |
| S. aureus ATCC 25923 | − | + | 105 |
| S. Enteritidis ATCC 13076 | − | + | 106 |
| S. Typhimurium UK-1 ATCC 68169 | − | + | 105 |
| S. Typhimurium ATCC 13311 | − | + | 106 |
Disclaimer/Publisher’s Note: The statements, opinions and data contained in all publications are solely those of the individual author(s) and contributor(s) and not of MDPI and/or the editor(s). MDPI and/or the editor(s) disclaim responsibility for any injury to people or property resulting from any ideas, methods, instructions or products referred to in the content. |
© 2023 by the authors. Licensee MDPI, Basel, Switzerland. This article is an open access article distributed under the terms and conditions of the Creative Commons Attribution (CC BY) license (https://creativecommons.org/licenses/by/4.0/).
Share and Cite
das Neves, M.d.S.; Scandorieiro, S.; Pereira, G.N.; Ribeiro, J.M.; Seabra, A.B.; Dias, A.P.; Yamashita, F.; Martinez, C.B.d.R.; Kobayashi, R.K.T.; Nakazato, G. Antibacterial Activity of Biodegradable Films Incorporated with Biologically-Synthesized Silver Nanoparticles and the Evaluation of Their Migration to Chicken Meat. Antibiotics 2023, 12, 178. https://doi.org/10.3390/antibiotics12010178
das Neves MdS, Scandorieiro S, Pereira GN, Ribeiro JM, Seabra AB, Dias AP, Yamashita F, Martinez CBdR, Kobayashi RKT, Nakazato G. Antibacterial Activity of Biodegradable Films Incorporated with Biologically-Synthesized Silver Nanoparticles and the Evaluation of Their Migration to Chicken Meat. Antibiotics. 2023; 12(1):178. https://doi.org/10.3390/antibiotics12010178
Chicago/Turabian Styledas Neves, Meiriele da S., Sara Scandorieiro, Giovana N. Pereira, Jhonatan M. Ribeiro, Amedea B. Seabra, Adriana P. Dias, Fabio Yamashita, Claudia B. dos R. Martinez, Renata K. T. Kobayashi, and Gerson Nakazato. 2023. "Antibacterial Activity of Biodegradable Films Incorporated with Biologically-Synthesized Silver Nanoparticles and the Evaluation of Their Migration to Chicken Meat" Antibiotics 12, no. 1: 178. https://doi.org/10.3390/antibiotics12010178
APA Styledas Neves, M. d. S., Scandorieiro, S., Pereira, G. N., Ribeiro, J. M., Seabra, A. B., Dias, A. P., Yamashita, F., Martinez, C. B. d. R., Kobayashi, R. K. T., & Nakazato, G. (2023). Antibacterial Activity of Biodegradable Films Incorporated with Biologically-Synthesized Silver Nanoparticles and the Evaluation of Their Migration to Chicken Meat. Antibiotics, 12(1), 178. https://doi.org/10.3390/antibiotics12010178

